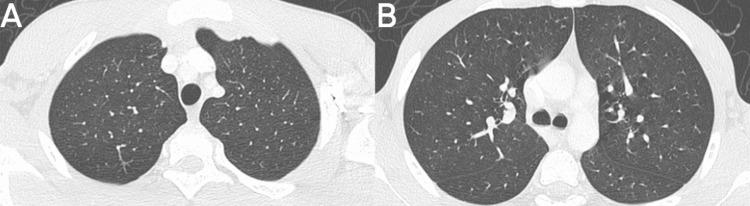

达托霉素诱发的嗜酸性粒细胞性肺炎
Eosinophilic Pneumonia Induced by Daptomycin.
作者信息
Ayala Torres Juan D, Noreña Brian, Suarez Poveda Alma Tatiana
机构信息
Radiology, Universidad de Antioquia, Medellín, COL.
出版信息
Cureus. 2024 Feb 27;16(2):e55095. doi: 10.7759/cureus.55095. eCollection 2024 Feb.
Daptomycin-induced eosinophilic pneumonia (DIEP) is a rare but serious complication associated with the use of this broad-spectrum antibiotic. We present the case of a teenager with a history of nasopharyngeal cancer who developed DIEP while receiving daptomycin to treat an infection associated with an implanted chamber catheter. Symptoms included recurrent dyspnea and peripheral eosinophilia, with radiological findings consistent with DIEP. The pathophysiology involves an immune response triggered by daptomycin, resulting in eosinophilic pulmonary inflammation. Diagnosis requires a thorough evaluation of medical history, clinical laboratory tests, and radiological findings. The main treatment involves discontinuation of daptomycin and, in severe cases, the use of steroids. It is essential to consider DIEP in patients with respiratory failure and bilateral pulmonary opacities who have used daptomycin and to suspect it in those with blood eosinophilia or in bronchoalveolar lavage.
达托霉素诱导的嗜酸性粒细胞性肺炎(DIEP)是一种与使用这种广谱抗生素相关的罕见但严重的并发症。我们报告了一名有鼻咽癌病史的青少年病例,该患者在接受达托霉素治疗与植入式腔静脉导管相关的感染时发生了DIEP。症状包括反复出现的呼吸困难和外周血嗜酸性粒细胞增多,影像学检查结果与DIEP一致。其病理生理学涉及由达托霉素触发的免疫反应,导致嗜酸性粒细胞性肺部炎症。诊断需要对病史、临床实验室检查和影像学检查结果进行全面评估。主要治疗方法包括停用达托霉素,在严重病例中使用类固醇。对于使用过达托霉素且出现呼吸衰竭和双侧肺部混浊的患者,必须考虑DIEP,对于有血嗜酸性粒细胞增多或支气管肺泡灌洗的患者应怀疑有DIEP。